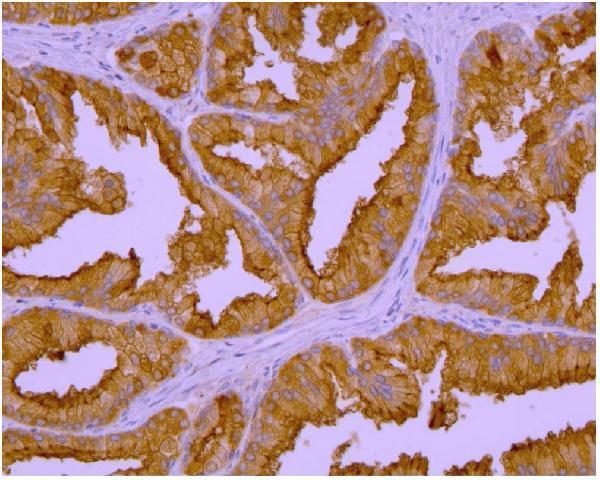
m02846 2 psma primary antibodies ihc testing 3

Product Info Summary
| SKU: | M02846-2 |
|---|---|
| Size: | 0.1 mg |
| Reactive Species: | Human, Mouse, Pig, Rat |
| Host: | Mouse |
| Application: | IHC-P, ICC, WB |
Customers Who Bought This Also Bought
Product info
Product Name
Anti-PSMA Purified FOLH1 Monoclonal Antibody
SKU/Catalog Number
M02846-2
Size
0.1 mg
Form
Liquid
Description
Boster Bio Anti-PSMA Purified FOLH1 Monoclonal Antibody (Catalog# M02846-2). Tested in WB, IHC-P, ICC application(s). This antibody reacts with Pig, Mouse, Rat, Human.
Storage & Handling
Store at 2-8°C. Do not freeze.
Cite This Product
Anti-PSMA Purified FOLH1 Monoclonal Antibody (Boster Biological Technology, Pleasanton CA, USA, Catalog # M02846-2)
Host
Mouse
Contents
Phosphate buffered saline (PBS), pH 7.4, 15 mM sodium azide
Clonality
Monoclonal
Clone Number
GCP-04
Isotype
Mouse IgG1
Immunogen
Recombinant fragment of human GCPII (amino acids 44-750) produced in S2 cells. The mouse monoclonal antibody GCP-04 recognizes amino acids 100-104 of extracellular domain of denaturated glutamate carboxypeptidase II (PSMA, NAALADase, FOLH1), an approximately 95-110 kDa transmembrane glycoprotein.
Cross-reactivity
This antibody does not cross-react with Thy-1.1 alloantigen.
Reactive Species
M02846-2 is reactive to FOLH1 in Human, Mouse, Pig, Rat
Observed Molecular Weight
42 kDa
Calculated molecular weight
84.3 kDa
Background of FOLH1
Glutamate carboxypeptidase II (GCPII), also known as N-acetyl-alpha-linked acidic dipeptidase I (NAALADase I), folate hydrolase (FOLH1), and prostate-specific membrane antigen (PSMA), is an approximately 95-110 kDa type II transmembrane glycoprotein expressed in various tissues. In nervous system GCPII cleaves abundant N-acetylaspartylglutamate, which is released from neurons in a calcium-dependent manner, to N-acetylaspartate and glutamate. As immoderate glutamate concentration is neurotoxic, GCPII contributes to pathological conditions regarding e.g. Alzheimer´s disease, Huntington´s disease, epilepsy, schizophrenia, stroke or neuropathic pain and appears to be an interesting therapeutic target. In jejunum GCPII hydrolyzes pteroylpoly-gamma-glutamate to folate and glutamate, enabling folate to be absorbed by gastrointestinal tract. GCPII, which is present in a number of tissues at low levels, is overexpressed in neovasculature of most solid tumours and is a target enzyme for diagnosis and treatment of prostate cancer. Normal human prostate express more mRNA coding for a cytosolic GCPII form truncated at the N-terminus (PSM´) than mRNA for membrane-bound GCPII, and this ratio is reversed upon malignant transformation.
Antibody Validation
Boster validates all antibodies on WB, IHC, ICC, Immunofluorescence, and ELISA with known positive control and negative samples to ensure specificity and high affinity, including thorough antibody incubations.
Application & Images
Applications
M02846-2 is guaranteed for IHC-P, ICC, WB Boster Guarantee
Assay Dilutions Recommendation
The recommendations below provide a starting point for assay optimization. The actual working concentration varies and should be decided by the user.
Western blotting: 1 μg/ml; positive control: LNCaP cell line. Sample preparation: Resuspend approx. 50 mil. cells in 1 ml cold lysis buffer (1% NP-40). Incubate 30 min on ice. Mix lysate with non-reducing/reducing Laemmli SDS-PAGE sample buffer. Both reducing and non-reducing conditions.
Validation Images & Assay Conditions

Click image to see more details
Immunohistochemistry staining of GCPII in human medulla oblongata by GCP-04 monoclonal antibody. Mag. 40x; positive astrocytes in white matter.
Click image to see more details
Immunohistochemistry staining of GCPII in human prostate by GCP-04 monoclonal antibody. Mag. 400x; positive epithelium of the prostate glands.

Click image to see more details
Immunohistochemistry staining of GCPII in porcine kidney by GCP-04 monoclonal antibody. Highly positive proximal glomeruli.

Click image to see more details
Western blotting analysis of human PSMA using mouse monoclonal antibody GCP-04 on lysates of LNCaP cell line and Jurkat cell line (PSMA non-expressing cell line; negative control) under reducing and non-reducing conditions. Nitrocellulose membrane was probed with 2 µg/ml of mouse anti-PSMA monoclonal antibody followed by IRDye800-conjugated anti-mouse secondary antibody.
Specific Publications For Anti-PSMA Purified FOLH1 Monoclonal Antibody (M02846-2)
Loading publications
Recommended Resources
Here are featured tools and databases that you might find useful.
- Boster's Pathways Library
- Protein Databases
- Bioscience Research Protocol Resources
- Data Processing & Analysis Software
- Photo Editing Software
- Scientific Literature Resources
- Research Paper Management Tools
- Molecular Biology Software
- Primer Design Tools
- Bioinformatics Tools
- Phylogenetic Tree Analysis
Customer Reviews
Have you used Anti-PSMA Purified FOLH1 Monoclonal Antibody?
Share your experimental results or join a short interview to earn up to $1,000 in product credits or other rewards.
0 Reviews For Anti-PSMA Purified FOLH1 Monoclonal Antibody
Customer Q&As
Have a question?
Find answers in Q&As, reviews.
Can't find your answer?
Submit your question




